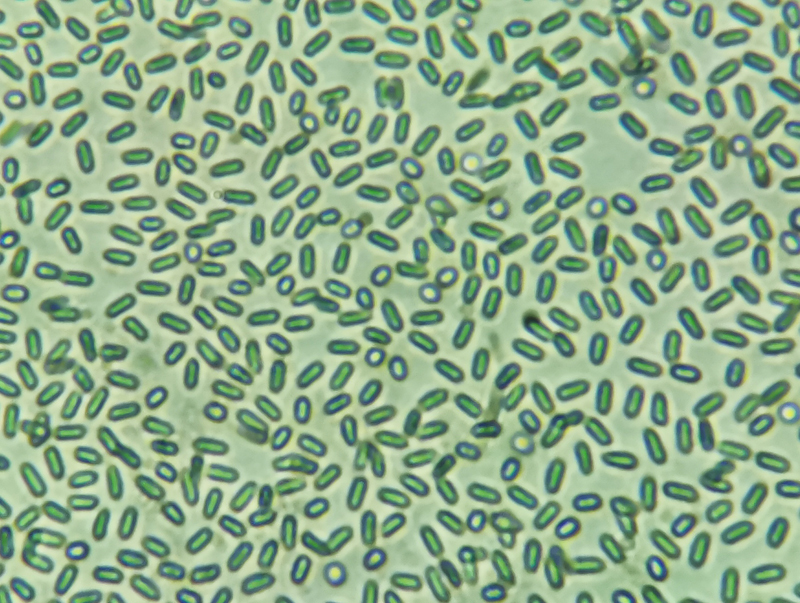

- 棘托竹荪
- 作者: 吕婧楠 四川沁和泉蘑菇园 2025年9月14日 四川乐山
-
- 【中文名】 棘托竹荪
- 【别 名】 长裙竹荪
- 【学 名】 Phallus echinovolvatus (M. Zang, D. R. Zheng & Z. X. Hu) Kreisel 1996
- 【生长环境】 竹林地上。
- 【分 布】 我国各地广泛栽培。
- 【采集地点】 四川省乐山市夹江县沁和泉蘑菇园内。
- 【经济价值】 可食蘑菇,已大量人工栽培。
- 【形态特征】
-
子实体较大, 其形态近似长裙竹荪。
-
菌盖近钟形,高3~3.5cm,宽3~4cm,薄而脆,具网格,有一层青褐色粘液,即孢体。
-
菌裙白色,长,网格呈多角形。网条密,柔软,纤细。
-
菌柄较长,海绵质,白色,长10~20cm,粗2.5~4cm。
-
菌托褐色或稍深,有少量残余刺状突起。中层有透明胶质,厚。
-
菌蛋呈球形或卵圆形,直径3~5cm。菌蛋初期白色,后颜色逐渐变深至深褐色。菌蛋基部菌索发达。表面遍布白色刺状突起组织,随着生长逐渐减少至表面光滑。伤不变色。
-
担孢子无色透明,呈椭圆形,3~4μm x 1.5~2μm。

-
【参考文献】
-
1. 贺新生.中国大型真菌物种名录.北京:中国农业出版社.2021
-
2. 卯晓岚.中国经济真菌.北京:科学出版社.1998:574.
欢迎浏览《常见蘑菇索引》,本版为方便手机浏览的简化版,更多蘑菇物种知识请在电脑上浏览,网址:moguyun.vip。





